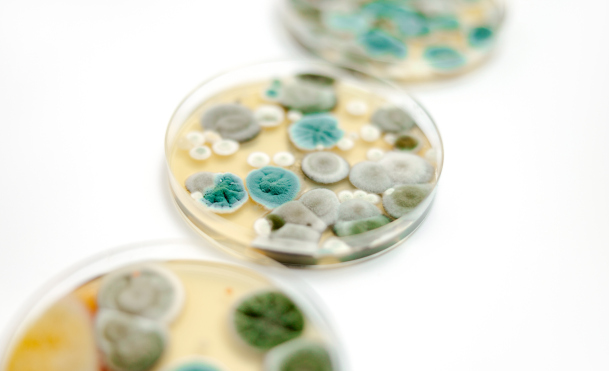

renovieren - gestalten - instand setzen
Ihr Objekt in guten Händen
Sie suchen einen Betrieb mit hervorragendem Preis-Leistungs-Verhältnis, für den Zuverlässigkeit, Sauberkeit und Kundenorientiertheit selbstverständlich sind?
Mit der Spezialisierung auf die Bereiche Wand - Decke - Boden biete ich Ihnen einen ganzheitlichen Service für die Umsetzung Ihrer Vorstellungen.
Zu meinen Schwerpunkten gehören insbesondere Wohnungs- und Gewerbeflächenrenovierungen, Raumflächengestaltungen sowie die fachgerechte Schimmelbeseitigung und Instandsetzung von Wasser- und Feuchteschäden in und an Gebäuden.

Natürliche Materialien und Baustoffe sind meine bevorzugte Wahl für ein gesundes Raumklima und Ihr Wohlbefinden.


Sie beabsichtigen, Ihren Räumlichkeiten eine neue Atmosphäre zu verleihen oder einfach nur Ihren Bestand zu renovieren?
Im Bereich Kreativtechniken und Wandgestaltung biete ich Ihnen
von Lasur- über Wisch- und Spachteltechniken das gesamte Spektrum an.
Die Umsetzung von modernen Farbkonzepten gehört ebenso zu meinen Fachgebieten wie die Renovierung Ihrer Räumlichkeiten in edlen Weißtönen.
Auch das Tapezieren von Rauhfaser- und Vliestapeten sowie das Verklinkern von Wandbereichen zählen zu meinen Leistungen.
Zudem gestalte ich Ihre Bodenflächen in verschiedensten Optiken.
Innovative indirekte Beleuchtungen übernehme ich ebenso wie die Ausstattung mit wunderschönen Natur- und Altholzelementen.
Natürliche und ökologisch einwandfreie Materialien, bevorzugt mineralische Systeme und Produkte mit dem Zertifikat "blauer Engel", sind für mich die erste Wahl. Ebenso verarbeiten ich altbewährte Lehm- und Kalkfarben für ein unübertroffenes Wohnklima und Ihre Gesundheit.

Sie haben einen Wasserschaden an oder in Ihrem Objekt?
Um weitere Schäden zu vermeiden, muss umgehend und fachgerecht gehandelt werden.
Ich berate Sie gerne kostenfrei und leiten alle notwendigen Schritte in die Wege.
Für die Erstmaßnahme stehen entsprechende Entfeuchtungsgeräte bereit. Für stark verschmutzte Flächen kann eine wasserfreie Reinigung mit Trockeneis-Strahlverfahren angewendet werden.
Auf Wunsch übernehme ich gerne die Koordination mit Gutachter oder Versicherung.
Die Sanierung nach WTA-Richtlinien mit hochwertigen Produkten, wie die der Firmen KEIM, Baumit und MKL, ist für mich selbstverständlich.
Sollten sich einmal ungebetene Besucher auf Ihren Wand- und Deckenflächen niedergelassen haben, bin ich Ihr Fachbetrieb zur Beseitigung des Schadens sowie der zugehörigen Ursache.
Auf Grund der gesundheitlichen Risiken haben Personenschutz und vorsorgliche Maßnahmen oberste Priorität.
Falls erforderlich werden entsprechende Schleusen- und Unterdrucksysteme eingerichtet.
Der TÜV-zertifizierte Sachkundenachweis im Bereich Wasserschadensanierung und Schimmelbeseitigung bestätigt den Anspruch, vorhandene Schäden fachgerecht zu beseitigen und den Ursprungszustand wiederherzustellen.
Ebenso übernehme ich präventive Maßnahmen um eine Schimmelproblematik gar nicht erst entstehen zu lassen. Darunter fallen zum Beispiel eine Taupunktermittlung der Gebäudeflächen sowie eine evtl. erforderliche Dämmung der Flächen mit Calziumsilikatplatten.

Sie möchten Ihre Immobilie selbst renovieren und gestalten?
Ich helfe Ihnen bei der "Qual der Wahl" und berate Sie in der Farbtonwahl sowie der passenden Produktauswahl.
Über ein vielfältiges Händlernetz liefere ich Ihnen die passenden Produkte.
Zusätzlich biete ich Ihnen die Möglichkeit der digitalen Farbgestaltung und entwickle mit Ihnen zusammen ein Farbkonzept anhand der originalen Objektbilder.

Sie planen, Ihre bestehenden Räumlichkeiten mit Trockenbauflächen umzugestalten oder Ihren Neubau entsprechend auszubauen?
Egal, ob es sich lediglich um ein paar Leitungen handelt, die "versteckt" werden sollen, kleine Schönheitsreparaturen an bestehenden Flächen oder ob Sie ein ganzes Stockwerk ausbauen möchten: Die Realisierung Ihre Vorstellungen ist mein Ziel.
Gerissene Wand- und Deckenflächen stellen auch kein Problem dar. Diese werden mit einem Spachtel- oder Klebevlies überarbeitet, so dass nach Fertigstellung keinerlei Spuren mehr sichtbar sind.
Sauberkeit ist selbstverständlich, bei Bedarf arbeite ich mit professioneller Unterdruck-Staubabsaugung.

Sie denken die Auftragsgröße ist zu gering, um eine Firma zu beauftragen? Ich komme auch mal kurz vorbei...
Ein paar Zentimeter Anschlussfuge erneuern, ein kleines Loch in der Wand vom Umzug schließen und an den Bestand anpassen oder abbröckelnder Putz am Haussockel - ich nehme mich der Sache gerne an.
Die Abrechnung erfolgt transparent nach Arbeitszeit und Material.
Mit mehr als 15 Jahren Erfahrung bin ich Ihr zuverlässiger, flexibler und kreativer Partner für die Realisierung Ihrer individuellen Wünsche im Raum Chiemgau bis München.
Eine Kooperation mit anderen Handwerksbetrieben zur Sicherung eines reibungslosen Ablaufs ist fester Bestandteil meiner Arbeit.
Kundenzufriedenheit ist meine tägliche Motivation.